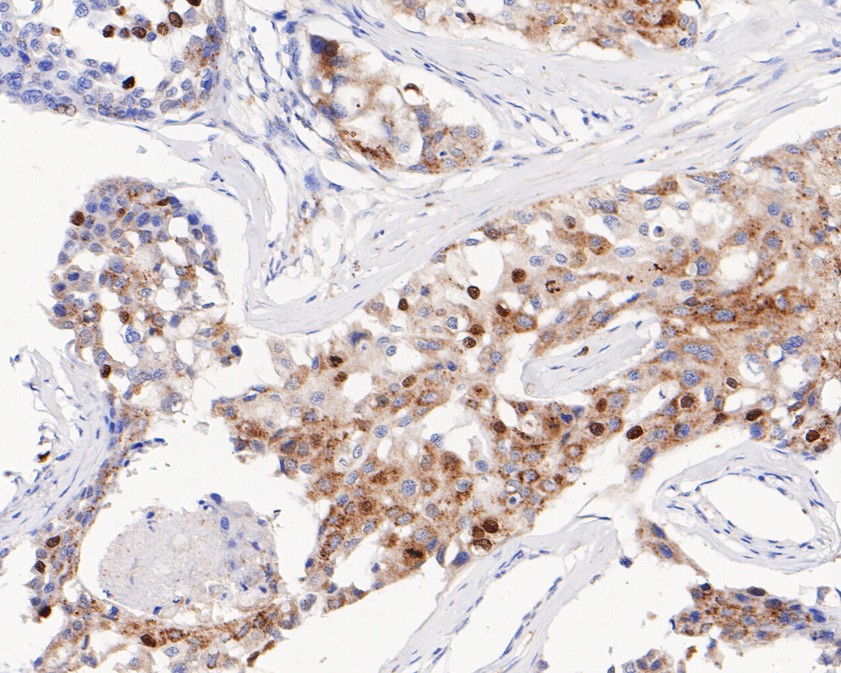

Catalog# ET1602-11
Phospho-Histone H1.3 (T17)+Histone H1.4 (T17) Recombinant Rabbit Monoclonal Antibody [SR38-03]
Application
-
WB
-
IF-Cell
-
IF-Tissue
-
IHC-P
Reactivity
-
Human
-
Mouse
Predicted reactivity
 预测的种属支持售后
预测的种属支持售后
-
Rat
This product has been cited in peer reviewed publications, see list HERE